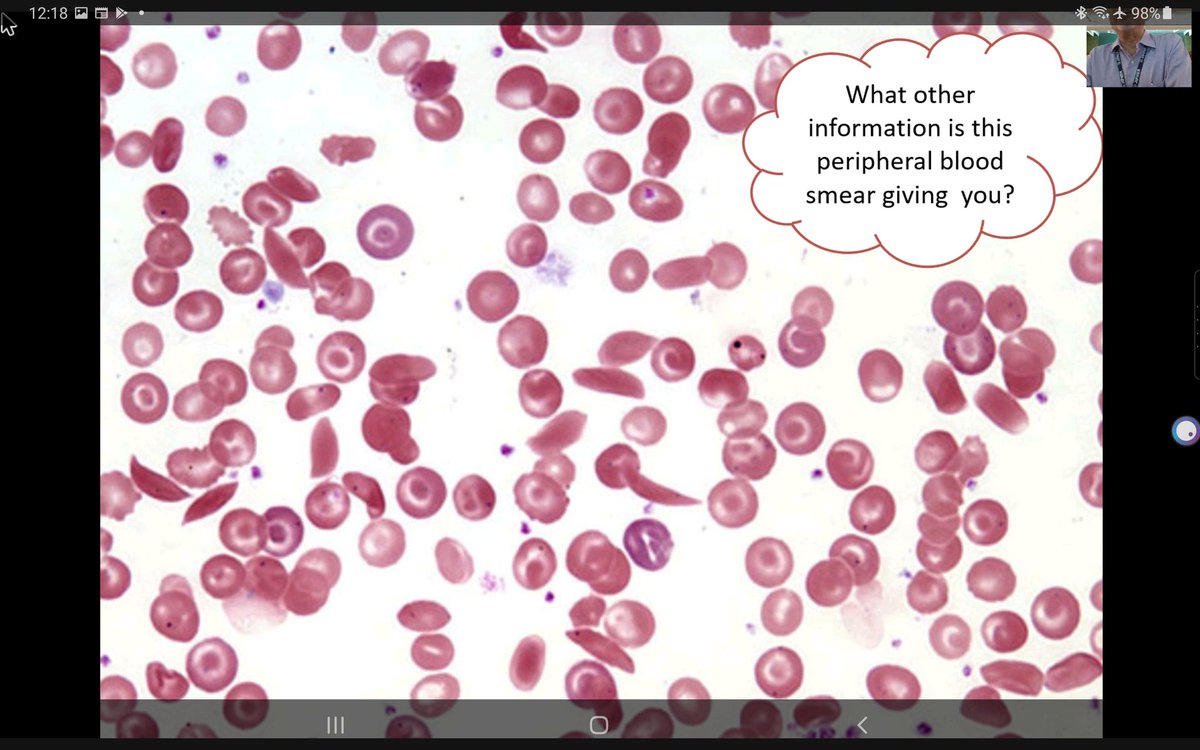
Importance of peripheral smear cannot be overemphasized!!!
Its crucial to diagnosis!!  #hematology #hemepath
Courtesy of Dr.Debdutta basu . #KAPCON2020 <a href="/vi_monappa/">Vidya Monappa</a> <a href="/padmapathology1/">Padma Priya J</a> <a href="/drsupriyatiwari/">Dr. Supriya Tiwari</a> <a href="/NippoPaul/">Nithin Paul NipPO</a> <a href="/anjuthevirgo/">Anju Pandey</a> <a href="/DrNithyashree/">Dr NithYASHree</a> <a href="/pathodoodles/">Pathodoodles by Deeksha Sikri</a>
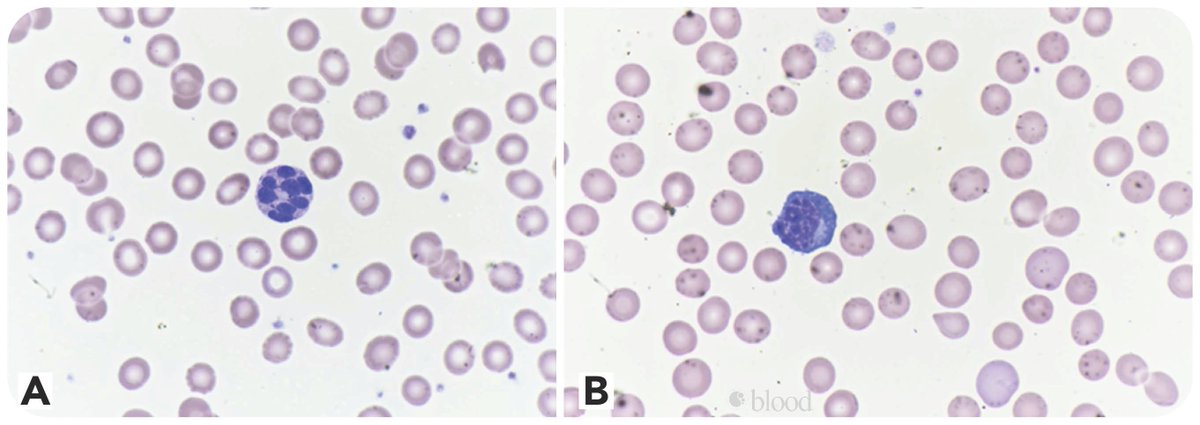
Hypersegmented granulocytes and COVID-19 infection ow.ly/tMJC50A6nxb #COVID19
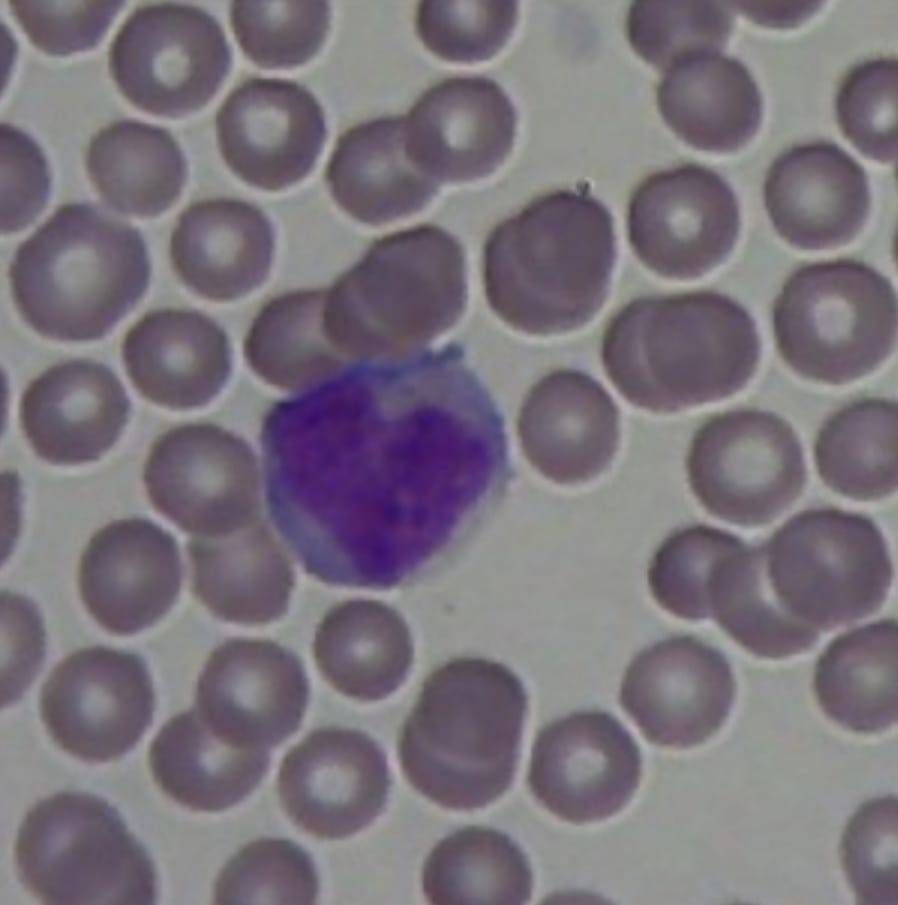
We scan with our heart 🔬🔬#mantiscope #hematology #pathology <a href="/mantiscope/">Mantiscope</a>
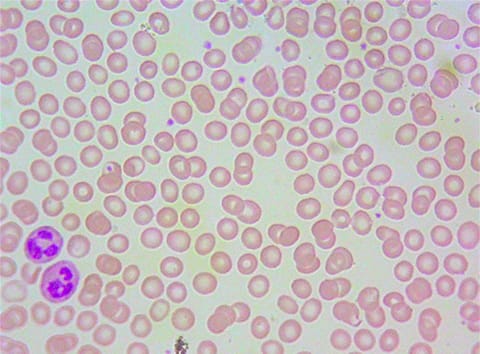
Our scanner searchs for morphological red and white blood cell abnormalities from the blood film via sampling in a number of images from the slide.

Mantiscope
@mantiscope
Medical Devices | Slide scanner with AI, cloud and IoT. |
Hacettepe Teknokent
mantiscope.com
ID: 1184402463631331328
16-10-2019 09:35:38
37 Tweet
37 Followers
93 Following




Importance of peripheral smear cannot be overemphasized!!! Its crucial to diagnosis!! #hematology #hemepath Courtesy of Dr.Debdutta basu . #KAPCON2020 Vidya Monappa Padma Priya J Dr. Supriya Tiwari Nithin Paul NipPO Anju Pandey Dr NithYASHree Pathodoodles by Deeksha Sikri